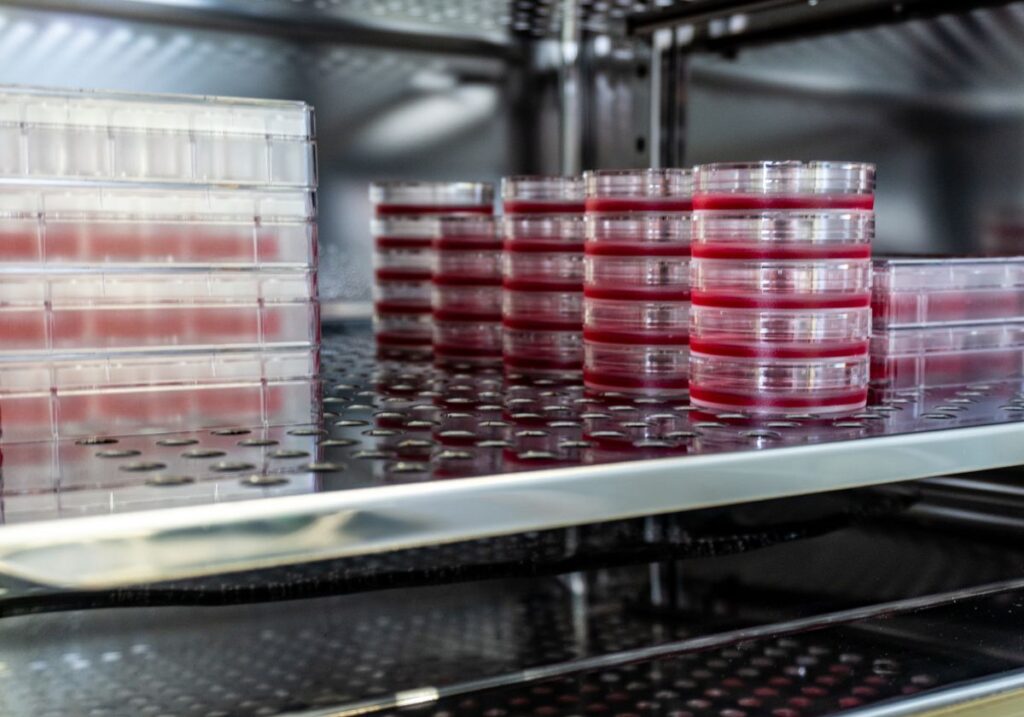
cell culture optimization

Getting cells to grow and thrive in culture involves finding the right conditions and developing the right protocols. This intricate balance is part of the bigger picture of cell culture optimization, a fundamental technique for various applications, from academic research to industrial manufacturing. Surprisingly, a staggering percentage of researchers deal with the challenges of optimizing cell cultures, as they must navigate external factors like contamination, workflow inefficiencies, and the logistics of scaling up processes. Understanding these dynamics can significantly enhance one’s ability to tackle common challenges in the field.
In this article, we will explore the essential aspects of cell culture optimization and provide valuable insights into creating ideal conditions for various cell types through innovative strategies. By the end, you’ll discover actionable steps and resources to enhance your experiments and streamline your workflows. Let’s dive in!
Understanding Cell Culture Optimization
Optimizing cell cultures is not merely about maintaining life; it’s about maximizing viability and productivity. To achieve this, researchers must focus on several crucial factors:
- Nutrient composition: The right media must be tailored to the specific needs of the cells.
- Environmental conditions: Temperature, pH levels, and CO2 concentrations can dramatically impact growth rates.
Utilizing protocols tailored to the unique characteristics of specific cell lines is a part of cell culture optimization. For example, mammalian cells typically require more careful handling compared to bacterial cultures due to their complex requirements. As highlighted in our article on cell culture basics, bringing forward the knowledge built on existing research can help mitigate some of the challenges faced in modern laboratory settings.
Mitigating Contamination Risks
Contamination remains one of the most pervasive issues in cell culture practices. It can derail even the best-laid experiments, leading to misleading results and wasted resources. Prioritizing contamination control can significantly improve outcomes, making it a crucial element of cell culture optimization. Some effective strategies include:
- Strict sterile techniques: Use sterile tools and ensure that all media are free of contaminants.
- Regular monitoring: Check for signs of microbial growth to address issues proactively.
For a deeper understanding of contamination prevention, refer to our white paper on preventing contamination in incubators which explores common cellular challenges faced by researchers.
Streamlining Workflows for Greater Efficiency
Efficiency in the laboratory is key to successful cell culture optimization. Researchers often face bottlenecks that can hinder their workflow. Implementing systematic approaches can alleviate these issues. Some recommended practices include:
- Automation: Use automated pipetting systems to reduce human error.
- Organizing workspaces: Keep materials organized to enhance speed and efficiency.
These practices can lead to significant time savings and improved reproducibility in results. For instance, automating cell handling processes is similar to strategies discussed in our analysis of biobased deepwell plates, which emphasizes improved workflow through effective design and automation.
The Impact of 3D Cell Culture Techniques
A breakthrough in cell culture optimization is the shift from traditional 2D cultures to 3D cell culture techniques. This change enhances physiological relevance and better mimics the natural environment of cells. The advantages include:
- Improved viability: Cells demonstrate higher survival rates in 3D cultures.
- Enhanced functionality: 3D cultures promote more accurate cellular behavior.
As explored in our featured article on the 3D cell culture revolution, this approach can dramatically transform experimental outcomes, allowing for better insights into cellular mechanisms.
Future Directions in Cell Culture Optimization
Innovation does not stop with current practices. The future holds promising advancements in cell culture optimization. Areas to watch include:
- AI integration: Using artificial intelligence to fine-tune culture parameters.
- Sustainable practices: Researching eco-friendly solutions that reduce laboratory waste.
By keeping abreast of emerging technologies, researchers can continually refine their methodologies. Harnessing new innovations, similar to those showcased in our analysis of automated genomic workflows, will be pivotal in driving sustainable science forward.
To deepen this topic, check our detailed analyses on Public Health section